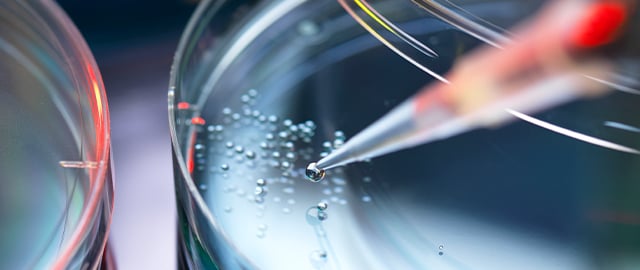

Our globally recognized Life Sciences practice is uniquely positioned to partner with innovators and investors operating in a fast-moving, tech-driven environment.
With more than 230 dedicated life sciences lawyers across all major sector hubs in the US, Europe, and Asia, we work with life sciences companies throughout the corporate life cycle — from startup to maturity — as well as investors, banks, and others in the life sciences ecosystem.
We understand the unique challenges life science companies face in securing funding, licensing and safeguarding intellectual property (IP), establishing partnerships, bringing new products to market, opening new revenue streams, and protecting existing product lines. We take a multidisciplinary approach to address clients’ challenges, drawing on our deep expertise across industries — such as technology, healthcare, real estate, and private equity — as well as the full spectrum of relevant practices.
Our comprehensive life sciences coverage includes:
- Complex financing and M&A transactions
- Capital market transactions advising issuers, sponsors, underwriters, and investors
- Life sciences collaborations and licensing
- Life sciences regulatory and compliance diligence and advisory services
- FDA litigation
- Patent prosecution, counseling, due diligence, and portfolio strategy
- IP litigation, including brand and generic patent, trade secret, trademark, and copyright litigation
- Products litigation
- Corporate governance
- High-stakes litigation
- Data, privacy, and cybersecurity
- Antitrust services for life sciences companies
- Employment
- Tax and other areas
Connect with our Life Sciences team and let us know how we can help.
Featured Resources and Years in Review
IPO Readiness at Goodwin

Resilience & Innovation: Goodwin Life Sciences in 2024

Securities Litigation Against Life Sciences Companies 2024 Year in Review
Antitrust & Competition Life Sciences Year in Review 2024

Contacts
- /en/people/b/bloom-mitchell

Mitchell S. Bloom
PartnerChair, Life Sciences - /en/people/t/taft-kingsley

Kingsley L. Taft
PartnerCo-Chair, Life Sciences - /en/people/c/cable-stuart

Stuart M. Cable
Vice Chair & Global Head of M&A

